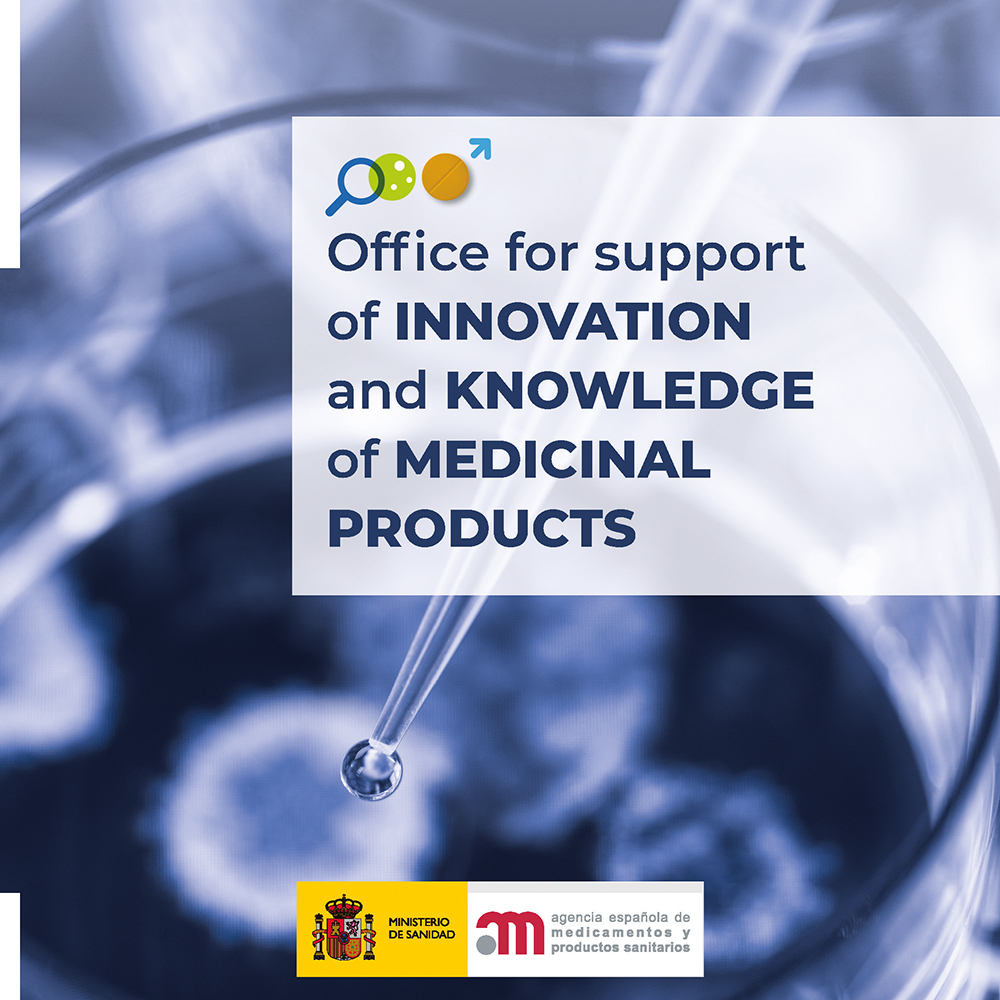

The Spanish Agency of Medicines and Medical Devices (AEMPS) created the Office for Support of Innovation and Knowledge of Medicinal Products (Innovation Office), in order to integrate, coordinate and strengthen the different activities and initiatives to support the research, innovation and to obtain additional knowledge about the authorized medicinal products.
The Innovation Office at the AEMPS was created with an integrated vision of the life cycle of the medicinal product. Access to medicinal products is considered from a global point of view that encompasses the promotion and support of research and development of new therapeutic alternatives which respond to the real needs of the population.
Thus, the services offered by the Innovation Office include, in addition to the support given to researchers and the coordination with the European Innovation Network (EU-IN), comprised of representatives from innovation offices within National Competent Authorities (NCA) and EMA’s Innovation Task Force (ITF), the generation of the knowledge on medicines, as well as, guarantee access to medicines in all their aspects.
National Scientific and/or Regulatory Advice

Objective: Regulatory and Scientific support by the AEMPS to the researchers of medicinal products on the different stages of their development.
-
Through the National Scientific Advice Unit
Target audience: For the pharmaceutical industry in general.
Information: National Scientific Advices
Contact: ascina@aemps.es
-
Through the Innovation Office
Target audience: For academic groups, independent researchers (from academia or hospitals), research foundations, patient foundations or non for profit organizations.
Information: Innovation Office
Contact: innov_spain@aemps.es
It includes the resolution of doubts about the classification of certain therapies as medicinal products or not, for example, about the classification of Advanced Therapies.
-
For queries involving only the Drug Inspection and Control Department (GMP (Good Manufacturing Practices)/GLP (Good Laboratory Practices))
Objective: Advice on the design of facilities, manufacturing processes and other aspects related to Good Manufacturing Practices (GMP).
Target audience: For academic groups, independent researchers (academics or hospitals), research foundations or companies non unauthorized as pharmaceutical laboratories.
Information: Fabricación de medicamentos
Contact: sgicm@aemps.es
-
For inquiries involving only the Medical Devices Department
Objective: Regulatory support from the AEMPS on the qualification and classification of health products and in vitro diagnostic health products as well as promoting innovation and support for research.
Target audience: Any natural or legal person who is developing medical devices or for whom the implementation of the regulations for medical devices and in vitro diagnostic medical devices involves a change in the qualification and classification of their products. Likewise, it can be used on those products that, due to the implementation of the regulations, fall within the list of products without an intended medical purpose included in Annex XVI.
Information: Consultations relating to the qualification and classification of medical devices and in vitro diagnostic medical devices: Consultas relativas a la cualificación y clasificación de productos sanitarios y productos sanitarios de diagnóstico in vitro
Contact: pscontrol@aemps.es / psdivcontrol@aemps.es
Simultaneous National Scientific Advice (SNSA)

Target audience: For the pharmaceutical industry in general and for academic groups, independent researchers (from academia or hospitals), research foundations, startups or patient foundations.
Information: SNSA (Asesorías Científicas Nacionales Simultáneas)
Contact: ascina@aemps.es
Centralized Scientific and/or Regulatory Advice (SAWP)

Objective: Participation of the AEMPS in European advices through the Scientific Advice Working Party (SAWP).
Target audience: For the pharmaceutical industry in general.
Information: Scientific Advice Working Party
Parallel joint scientific consultation with regulators and health technology assessment bodies

Objective: To allow medicine developers to obtain feedback from regulators and health technology assessment (HTA) bodies in European Union (EU) Member States on their evidence-generation plans to support decision-making on marketing authorisation and reimbursement of new medicines at the same time.
Target audience: For the pharmaceutical industry in general and for academic groups, independent researchers (from academia or hospitals), research foundations, startups or patient foundations.
Information: Parallel joint scientific consultation with regulators and health technology assessment bodies
Contact: hta@aemps.es
EU-Innovation Network (EU-IN): comprised of representatives from innovation offices within NCAs and EMA’s Innovation Task Force (ITF).
Objective: Strengthen collaboration between National Competent Authorities and the EMA to address regulatory issues related to emerging therapies and technologies.
Information: EU-Innovation Network (EU-IN) (hma.eu)


To obtain a National Scientific Advice with more than one National Competent Authority at the same time.

Identification of emerging trends of innovative medicinal products and health technologies which will require to be regulated on an harmonized way among Member States.

To support non-for-profit organisations and academia and hospital researchers to gather or generate sufficient evidence on the use of an established medicine and used off-label, on which a future application made by a pharmaceutical company is based on. New treatment options are offered to patients.

Borderline and classification (BLCG)
To discuss and share non-binding opinions on borderline classification issues. “Borderline classification” in the context of this group is understood as referring to circumstances where a product is not clearly covered by the pharmaceutical legal framework/regulation due to the nature of the product.
Contact: innov_spain@aemps.es
-
Research with medicines for Human Use. Clinical trials with medicines.
Objective: Early access to investigational medicinal products.
Target audience: Patients and patient associations, healthcare professionals, research managers, independent researchers (academic or hospital) and industry.
Information: Research with medicines for human use
Contact: aecam@aemps.es
-
Compassionate use of investigational medicinal products.
Objective: Access to investigational medicinal treatments where appropriate.
Target audience: Patients and patient associations, healthcare professionals, healthcare centers.
Information: Acceso a medicamentos en situaciones especiales
Contact: medicamentosespeciales@aemps.es
-
Therapeutic positioning report.
Objective: Determine the therapeutic value of new medicinal product compared to their alternatives on the market.
Target audience: Health authorities, patient associations, scientific societies, new medicinal products developers.
Information: Informes de posicionamiento terapéutico
Contact: ipt@aemps.es
-
Recommendations for the use of authorised medicines under different conditions of the already stablished in their Summary of Product Characteristics (Smpc).
Objective: Elaborate such recommendations.
Target audience: Healthcare professionals, healthcare centers, autonomous regions, patients.
Information: Acceso a medicamentos en situaciones especiales
Contact: medicamentosespeciales@aemps.es